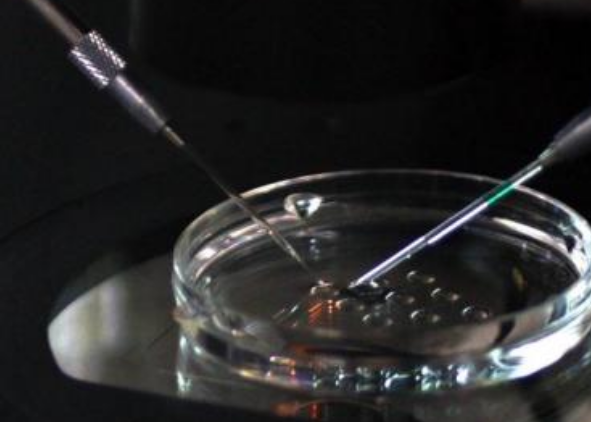
絕經后女性可以做試管嬰兒嗎 40歲試管嬰兒的成功率多大 絕經后女性可以做試管嬰兒嗎 40歲試管嬰兒的成功率多大

時間:2018-05-09 19:42:11來源:本站整理作者:zl點擊:
有很多大齡女性也想要通過試管嬰兒來要一個孩子,那么絕經后女性可以做試管嬰兒嗎,40歲試管嬰兒的成功率多大,下面八寶網的小編就來為大家介紹。
只要身體條件可耐受妊娠,理論上絕經后女性可以通過贈卵方式獲得妊娠,但是由于國內只允許做試管嬰兒的女性自愿贈送卵子,所以卵子來源極少,一般生殖中心不接受贈卵的預約。

由于每個人的卵巢功能不同,不孕原因也不一樣,所以使用的促排卵藥物多少和治療時間長短也不一樣。醫生會根據每位患者的具體情況制定科學有效的治療方案。因此,試管嬰兒治療的費用因人而異。

試管嬰兒的成功率由很多因素決定,其中最重要的因素就是年齡。
女性在35 歲以后,生育能力逐漸下降,出現卵泡減少、卵子質量也逐漸下降,過了40 歲下降更加明顯。有研究顯示,38 歲后的女性每排出10 個卵子,只有3 個是正常的,這意味著除了懷孕的機會逐漸減少,流產和異常孩子出生的概率會增加。
同樣,如果35 歲以后生育有困難需要通過試管嬰兒技術助孕,成功率也是逐漸下降的。
網友跟帖
Copyright 2015-2020 8bb.com 〖八寶網〗 版權所有 鄂ICP備19016373號-1
聲明: 本站文章均來自互聯網,不代表本站觀點 如有異議 請與本站聯系 本站為非贏利性網站 不接受任何贊助和廣告
網友評論僅供其表達個人看法,并不表明八寶網立場。